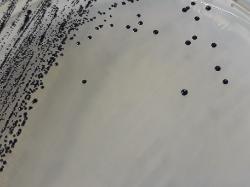

| Staphylococcus aureus producing shiny black colonies |
REFERENCES
1. Helgomar Raducanescu, Valeria Bica-Popii: Bacteriologie veterinara. Ed. Ceres,
326, 1986.
2. Alexandru Rafila: Medii de cultura, medii de transport si conservare. In Dumitru
Buiuc, Marian Negut: Tratat de microbiologie clinica ed. III, 2009, 1045-1084.
3. Handbook Culture Media Merck, 1982.
4. Himedia Laboratories. Baird Parker Agar Base (FPT) - technical data.
1. Helgomar Raducanescu, Valeria Bica-Popii: Bacteriologie veterinara. Ed. Ceres,
326, 1986.
2. Alexandru Rafila: Medii de cultura, medii de transport si conservare. In Dumitru
Buiuc, Marian Negut: Tratat de microbiologie clinica ed. III, 2009, 1045-1084.
3. Handbook Culture Media Merck, 1982.
4. Himedia Laboratories. Baird Parker Agar Base (FPT) - technical data.
COMPOSITION
Peptone from casein 10.0 g, meat extract 5.0 g, Yeast extract 1.0 g, sodium pyruvate
10.0 g, glycine 12.0 g, lithium chloride 5.0 g, agar-agar 15.0 g, egg-yolk emulsion 50
ml, potassium tellurite 0.105 g, distilled water ad 1000 ml, pH 6.8 ± 0.2
Optional (for Proteus inhibition): sulfamethazine 0.05 g
Add glycine, potassium tellurite, egg-yolk emulsion & sulfamethazine after
autoclaving and cooling to 45-50 ºC. Pour in plates. Can be stored 1 month at 4 ºC.
Egg-yolk solution preparation: harvest sterile yolks (see lecithinase test) and mix
3:7 (volumes) with physiological saline solution.
PROCEDURE
Inoculate medium by spreading the strain on surface and incubate 24-48 hours at
37 ºC.
RESULTS
Staphylococcus forms gray/black shiny, convex colonies, 1-5 mm in diameter, with a
narrow white edge, surrounded by a 2-5 mm clear zone. After 48 hours opaque
rings within the clear zone may appear.
Micrococci form very small, brown to black colonies, no clear zones.
Bacillus species form dark brown colonies, clear zones sometimes appear after 48
hours.
Yeasts form white colonies & no clear zones.
MEDIUM VARIANT
A variant of the initial Baird-Parker medium differs in that the egg yolk emulsion has
been replaced by fibrinogen, rabbit plasma and trypsin inhibitor. The fibrinogen was
added to enhance the coagulase reaction in the medium. The addition of rabbit
plasma was found to be more specific for the coagulase activity when compared to
other sources of plasma. Trypsin inhibitor was added to prevent fibrinolysis.
WARNINGS
Potassium tellurite and lithium chloride are harmful. Avoid all bodily contact and
inhalation of vapours. On contact with skin wash with plenty of water immediately.
Peptone from casein 10.0 g, meat extract 5.0 g, Yeast extract 1.0 g, sodium pyruvate
10.0 g, glycine 12.0 g, lithium chloride 5.0 g, agar-agar 15.0 g, egg-yolk emulsion 50
ml, potassium tellurite 0.105 g, distilled water ad 1000 ml, pH 6.8 ± 0.2
Optional (for Proteus inhibition): sulfamethazine 0.05 g
Add glycine, potassium tellurite, egg-yolk emulsion & sulfamethazine after
autoclaving and cooling to 45-50 ºC. Pour in plates. Can be stored 1 month at 4 ºC.
Egg-yolk solution preparation: harvest sterile yolks (see lecithinase test) and mix
3:7 (volumes) with physiological saline solution.
PROCEDURE
Inoculate medium by spreading the strain on surface and incubate 24-48 hours at
37 ºC.
RESULTS
Staphylococcus forms gray/black shiny, convex colonies, 1-5 mm in diameter, with a
narrow white edge, surrounded by a 2-5 mm clear zone. After 48 hours opaque
rings within the clear zone may appear.
Micrococci form very small, brown to black colonies, no clear zones.
Bacillus species form dark brown colonies, clear zones sometimes appear after 48
hours.
Yeasts form white colonies & no clear zones.
MEDIUM VARIANT
A variant of the initial Baird-Parker medium differs in that the egg yolk emulsion has
been replaced by fibrinogen, rabbit plasma and trypsin inhibitor. The fibrinogen was
added to enhance the coagulase reaction in the medium. The addition of rabbit
plasma was found to be more specific for the coagulase activity when compared to
other sources of plasma. Trypsin inhibitor was added to prevent fibrinolysis.
WARNINGS
Potassium tellurite and lithium chloride are harmful. Avoid all bodily contact and
inhalation of vapours. On contact with skin wash with plenty of water immediately.
DESCRIPTION
The medium contains pyruvate and glycine which stimulate the growth of
staphylococci; also contains lithium chloride and tellurite which inhibit the growth of
other germs. It is used for detection from foods and pharmaceutical products.
Staphylococus colonies show two characterisitic features when grown on this
medium:
1. forming characteristic zones and rings due to lipolysis (egg-yolk content) and
proteolysis;
2. producing a black color because of the tellurite.
The medium contains pyruvate and glycine which stimulate the growth of
staphylococci; also contains lithium chloride and tellurite which inhibit the growth of
other germs. It is used for detection from foods and pharmaceutical products.
Staphylococus colonies show two characterisitic features when grown on this
medium:
1. forming characteristic zones and rings due to lipolysis (egg-yolk content) and
proteolysis;
2. producing a black color because of the tellurite.
| Baird-Parker Agar |
| Egg-yolk emulsion |
(c) Costin Stoica
| Antibiogram |
| Encyclopedia |
| Culture media |
| Biochemical tests |
| Stainings |
| Images |
| Movies |
| Articles |
| Identification |
| Software |
| R E G N U M PROKARYOTAE |
| Back |
| Baird Parker Agar |